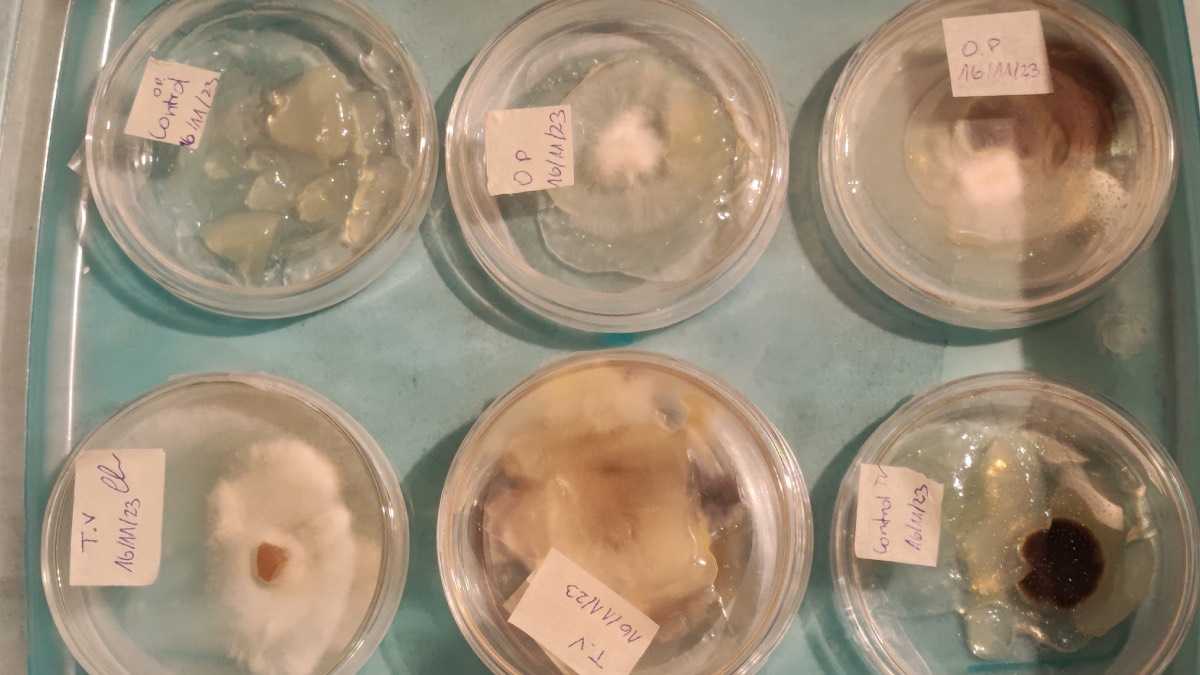
archivo infogate web-5-2-34-61

- Un equipo de investigadores de esta universidad estatal desarrolla materiales de construcción a partir de materias primas renovables y residuos agroindustriales, promoviendo una economía circular y reduciendo significativamente el impacto ambiental de la industria de la construcción.
-
Los biomateriales que se generan como el aislante termoacústico a base de micelios de hongos, no sólo igualan las propiedades de los elementos tradicionales como el poliestireno expandido, sino que los superan en resistencia al fuego y humedad, ofreciendo una alternativa más segura y eficiente.
-
El proyecto, iniciado como una tesis de pregrado, ha crecido con el apoyo del Hub de Innovación de la UTEM, demostrando el compromiso de la institución con la investigación y el desarrollo sostenible, posicionándose como un referente en la innovación sostenible en construcción.
Imaginemos un futuro donde nuestras casas no solo protejan del clima, sino que también cuiden del planeta. Este es el objetivo de los biomateriales que se están desarrollando en la Universidad Tecnológica Metropolitana (UTEM). Utilizando micelios de hongos y residuos agroindustriales como corontas de choclo, residuos de trigo y algas, crean aislantes termoacústicos que no sólo igualan la resistencia térmica del poliestireno expandido, sino que lo superan en resistencia al fuego.
La investigación en biomateriales que desarrolla la citada casa de estudios estatal aporta a un mundo que lucha contra el cambio climático. Con cada avance, se da un paso más hacia un futuro en el que las construcciones no sólo sean refugios, sino que también guardianes del medio ambiente. Como dice el refrán, "de la basura al tesoro", y en este caso, los biomateriales constituyen la ganancia que promete revolucionar la construcción sostenible.
El proyecto es liderado por la investigadora Suzanne Segeur de la UTEM, junto a un equipo conformado por los profesionales de la misma casa de estudios Alan Huircaman Mackay, Maarah Madrid, Paula Nuñez, Nina Meneses y Paulo Varas. Esta investigación impacta la industria de la construcción con materiales sostenibles y de alto rendimiento, utilizando residuos agroindustriales y algas.
"La industria de la construcción es una de las más contaminantes del mundo, con gran impacto en el medio ambiente desde que se obtienen las materias primas hasta que la edificación llega al fin de su vida útil. La búsqueda de materiales más sustentables basados en materias primas renovables permitiría minimizar ese impacto negativo y asegurar los recursos naturales para nuestras futuras generaciones", afirma Ségeur.
En un mundo en el que la sostenibilidad es cada vez más necesaria, dicha investigación está marcando un antes y un después en el sector de la construcción. Con un enfoque sustentable, Ségeur y su equipo están desarrollando materiales que no solo prometen reducir el impacto ambiental, sino que también muestran propiedades superiores a los tradicionales.
Desafíos, promesas e innovación sostenible
La propuesta innova en materiales y también en procesos. Al utilizar desechos agroindustriales y algas varadas en la costa, convierten lo que antes era basura en recursos valiosos. Este enfoque no solo reduce la cantidad de residuos que terminan en vertederos, sino que también promueve una economía circular, en que los materiales pueden ser reutilizados y reciclados al final de su vida útil.
Como en toda gran aventura, el camino hacia la sostenibilidad no está exento de desafíos. La obtención de materias primas y la resistencia al cambio en la industria son obstáculos que Ségeur y el equipo UTEM enfrentan con determinación. Los resultados prometedores de sus pruebas de fuego, compresión y humedad indican que están en el camino correcto. En pruebas comparativas, mientras el poliestireno se derretía bajo la llama, el micelio se transformaba en carbón, demostrando una sorprendente resistencia.
Aunque estos biomateriales aún no están disponibles comercialmente, el equipo UTEM trabaja para que pronto puedan ser una opción viable en el mercado. Mientras tanto, materiales como “roots” (aislamiento térmico de raíces de trigo) y “lanarq” (un aislamiento térmico de lana de oveja) ya están disponibles en Chile, ofreciendo alternativas más sostenibles a los constructores y propietarios de viviendas.
Lo que comenzó como una tesis de pregrado ha crecido hasta convertirse en un esfuerzo colaborativo apoyado por el hub de innovación de la UTEM. El equipo de investigadores comprometidos trabaja para transformar la industria de la construcción y asegurar un futuro más verde para las próximas generaciones.